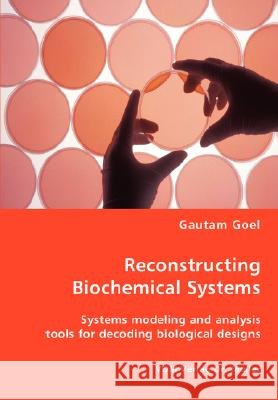
Reconstructing Biochemical Systems - Systems modeling and analysis tools for decoding biological designs Goel, Gautam 9783836458788 VDM VERLAG DR. MUELLER E.K. - książka

Reconstructing Biochemical Systems - Systems modeling and analysis tools for decoding biological designs » książka
topmenu
Reconstructing Biochemical Systems - Systems modeling and analysis tools for decoding biological designs
ISBN-13: 9783836458788 / Angielski / Miękka / 2008 / 144 str.
Reconstructing Biochemical Systems - Systems modeling and analysis tools for decoding biological designs
ISBN-13: 9783836458788 / Angielski / Miękka / 2008 / 144 str.
cena 275,01
(netto: 261,91 VAT: 5%)
Najniższa cena z 30 dni: 267,52
(netto: 261,91 VAT: 5%)
Najniższa cena z 30 dni: 267,52
Termin realizacji zamówienia:
ok. 16-18 dni roboczych.
ok. 16-18 dni roboczych.
Darmowa dostawa!
Kategorie:
Kategorie BISAC:
Wydawca:
VDM VERLAG DR. MUELLER E.K.
Język:
Angielski
ISBN-13:
9783836458788
Rok wydania:
2008
Ilość stron:
144
Waga:
0.24 kg
Wymiary:
24.41 x 16.99 x 0.79
Oprawa:
Miękka
Wolumenów:
01